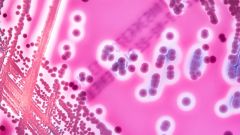
Что такое инфекция, вызванная стрептококком группы В?

Что такое инфекция, вызванная стрептококком группы В?
Стрептококки группы B (GBS, или СГB) вызывают опасные инфекции у новорожденных (сепсис новорожденных), а также инфекции в суставах (септический артрит) и сердце (эндокардит).
До 1964 года СГB не рассматривались как патоген человека. Однако на сегодняшний день стрептококки группы B были признаны основными бактериальными патогенами в перинатальных инфекциях.
Бактерии, носителем которых выступают до 40% взрослых, обычно находятся в кишечнике и у 25% женщин во влагалище, как правило, не вызывая никаких симптомов.
Согласно статистике, у одного на 1000 детей развивается инфекция, вызванная стрептококком группы В. СГB-инфекции обычно поражают новорожденных, иногда взрослых и очень редко — детей во время беременности и родов. Эта инфекция не относится к инфекциям, передающимся половым путем, и не передается через еду или воду.
У младенцев часто наблюдаются инфекции с ранним началом, вызванные стрептококком группы В. Они намного более распространены и встречаются в возрасте до шести дней при контакте с бактерией внутриутробно или во время родов.
Инфекции, вызванные стрептококком группы В, с поздним началом развиваются в возрасте от шести дней до трех месяцев и обычно вызывают сепсис и менингит.
Симптомы у детей следующие:
- Лихорадка.
- Синюшная окраска кожи (цианоз).
- Судороги.
- Вялость или ригидность.
- Рвота.
- Трудности с кормлением ребенка.
- Диарея.
- Беспокойство.
У взрослых могут наблюдаться инфекции:
- Кожи и мягких тканей.
- Костей и суставов.
- Легких.
- Мочевыводящих путей.
Инфекции, вызванные стрептококком группы В, связаны с мертворождением, преждевременными родами и инфекциями у матерей. Лечение пациентов любого возраста проводится внутривенным введением антибиотиков под наблюдением специалистов.
Антибиотики в таблетках и травы не доказали свою эффективность. До сих пор существует еще одна проблема: бактерии могут жить в кишечнике и снова возвращаться после курса антибиотиков. Вероятно, в будущем будет разработана вакцина для профилактики СГВ-инфекции.
Помните! Необходимо своевременно сдать анализы для определения стрептококка группы B, особенно если вы на третьем триместре беременности. Если вы не прошли анализ на стрептококк, врач назначит специфическое лечение антибиотиками.